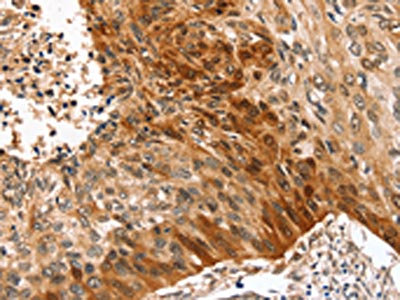

SYNPO2 Antibody
-
中文名稱:SYNPO2兔多克隆抗體
-
貨號:CSB-PA461485
-
規(guī)格:¥1100
-
圖片:
-
The image on the left is immunohistochemistry of paraffin-embedded Human brain tissue using CSB-PA461485(SYNPO2 Antibody) at dilution 1/50, on the right is treated with synthetic peptide. (Original magnification: ×200)
-
The image on the left is immunohistochemistry of paraffin-embedded Human esophagus cancer tissue using CSB-PA461485(SYNPO2 Antibody) at dilution 1/50, on the right is treated with synthetic peptide. (Original magnification: ×200)
-
-
其他:
產(chǎn)品詳情
-
Uniprot No.:
-
基因名:SYNPO2
-
別名:DKFZp686G051 antibody; Genethonin 2 antibody; Genethonin-2 antibody; Myopodin antibody; striated muscle specific antibody; Synaptopodin-2 antibody; SYNP2_HUMAN antibody; SYNPO 2 antibody; Synpo2 antibody
-
宿主:Rabbit
-
反應(yīng)種屬:Human
-
免疫原:Synthetic peptide of Human SYNPO2
-
免疫原種屬:Homo sapiens (Human)
-
標記方式:Non-conjugated
-
抗體亞型:IgG
-
純化方式:Antigen affinity purification
-
濃度:It differs from different batches. Please contact us to confirm it.
-
保存緩沖液:-20°C, pH7.4 PBS, 0.05% NaN3, 40% Glycerol
-
產(chǎn)品提供形式:Liquid
-
應(yīng)用范圍:ELISA,IHC
-
推薦稀釋比:
Application Recommended Dilution ELISA 1:2000-1:5000 IHC 1:25-1:100 -
Protocols:
-
儲存條件:Upon receipt, store at -20°C or -80°C. Avoid repeated freeze.
-
貨期:Basically, we can dispatch the products out in 1-3 working days after receiving your orders. Delivery time maybe differs from different purchasing way or location, please kindly consult your local distributors for specific delivery time.
-
用途:For Research Use Only. Not for use in diagnostic or therapeutic procedures.
相關(guān)產(chǎn)品
靶點詳情
-
功能:Has an actin-binding and actin-bundling activity. Can induce the formation of F-actin networks in an isoform-specific manner. At the sarcomeric Z lines is proposed to act as adapter protein that links nascent myofibers to the sarcolemma via ZYX and may play a role in early assembly and stabilization of the Z lines. Involved in autophagosome formation. May play a role in chaperone-assisted selective autophagy (CASA) involved in Z lines maintenance in striated muscle under mechanical tension; may link the client-processing CASA chaperone machinery to a membrane-tethering and fusion complex providing autophagosome membranes. Involved in regulation of cell migration. May be a tumor suppressor.; Involved in regulation of cell migration. Can induce formation of thick, irregular actin bundles in the cell body.; Involved in regulation of cell migration. Can induce long, well-organized actin bundles frequently orientated in parallel along the long axis of the cell showing characteristics of contractile ventral stress fibers.; Involved in regulation of cell migration. Can induce an amorphous actin meshwork throughout the cell body containing a mixture of long and short, randomly organized thick and thin actin bundles.; Can induce long, well-organized actin bundles frequently orientated in parallel along the long axis of the cell showing characteristics of contractile ventral stress fibers.; Involved in regulation of cell migration in part dependent on the Rho-ROCK cascade; can promote formation of nascent focal adhesions, actin bundles at the leading cell edge and lamellipodia. Can induce formation of thick, irregular actin bundles in the cell body; the induced actin network is associated with enhanced cell migration in vitro.
-
基因功能參考文獻:
- These findings uncover a suppressive role of SYNPO2 in triple-negative breast cancer (TNBC) metastasis via inhibition of YAP/TAZ, and suggest that SYNPO2 might provide a potential prognosis marker and novel therapeutic strategy. PMID: 28991374
- LMOD1, SYNPO2, PDLIM7, PLN, and SYNM down-regulation reflect the altered phenotype of smooth muscle cells in vascular disease and could be early sensitive markers of SMC dedifferentiation. PMID: 27470516
- Results show that SYNPO2 gene plays an important role in the etiology of epithelial ovarian cancer, suggesting that this gene may be a potential genetic modifier for developing epithelial ovarian cancer. PMID: 28231729
- High Myopodin methylation is associated with metastasis in kidney cancer. PMID: 27592258
- High Synaptopodin-2 induces assembly of peripheral actin bundles and immature focal adhesions to promote lamellipodia formation and prostate cancer cell migration. PMID: 25883213
- Promoter hypermethylation and down regulation of SYNPO2 has significance in the prognosis of melanoma patients. PMID: 25918983
- myopodin is epigenetically modified in colon cancer PMID: 22252522
- the N-terminus of myopodin binds integrin-linked kinase (ILK) both in vivo and in vitro PMID: 21643011
- myopodin functions as a tumor suppressor gene to limit the growth and to inhibit the metastasis of cancer cells PMID: 15111326
- Imp13 functions in myopodin import and the regulation of this event is critical for normal and abnormal cellular differentiation. PMID: 17828378
- The myopodin new isoform (Myo2), in addition to the two predicted isoforms (Myo1 and Myo3), are transcribed in various mammalian tumor cell lines. PMID: 18371299
- The subcellular localization of myopodin is involved in its suppressor or activator function in tumorigenesis. PMID: 19360353
顯示更多
收起更多
-
亞細胞定位:Nucleus. Cytoplasm. Cytoplasm, cytoskeleton. Cytoplasm, myofibril, sarcomere, Z line. Cell junction, focal adhesion.; [Isoform 1]: Cytoplasm, cytoskeleton.; [Isoform 2]: Cytoplasm, cytoskeleton.; [Isoform 3]: Cytoplasm, cytoskeleton.; [Isoform 4]: Cytoplasm, cytoskeleton.; [Isoform 5]: Cytoplasm, cytoskeleton.
-
蛋白家族:Synaptopodin family
-
組織特異性:Expressed in heart muscle. Isoform 5 is specifically expressed in skeletal muscle.
-
數(shù)據(jù)庫鏈接:
Most popular with customers
-
-
YWHAB Recombinant Monoclonal Antibody
Applications: ELISA, WB, IHC, IF, FC
Species Reactivity: Human, Mouse, Rat
-
Phospho-YAP1 (S127) Recombinant Monoclonal Antibody
Applications: ELISA, WB, IHC
Species Reactivity: Human
-
-
-
-
-